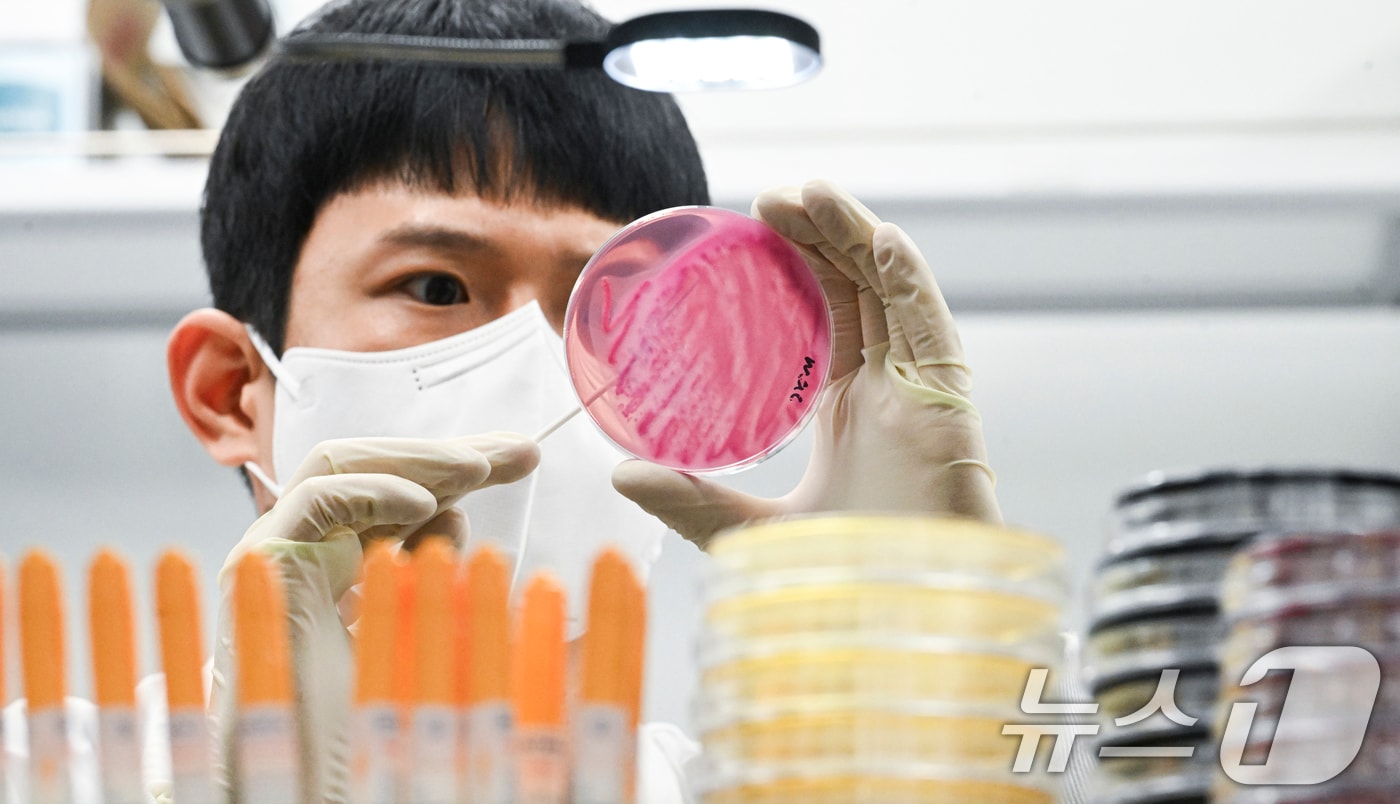
(사진은 기사 내용과 무관함) / 뉴스1 ⓒ News1

인천 고교서 35명 설사·복통 '집단 식중독 의심'…역학조사 착수
- 정진욱 기자
(인천=뉴스1) 정진욱 기자 = 인천의 한 고등학교에서 학생 35명이 설사와 복통 등 식중독 의심 증상을 보여 인천시가 역학 조사에 착수했다.
3일 시에 따르면 인천시는 전날 해당 학교에서 관련 증상이 나타났단 신고를 접수하고 학생 36명의 검체와 급식 보존식을 채취해 원인 규명에 나섰다. 검사 결과는 2주 후 나올 예정이다.
학교 측도 급식실 등 교내 전 시설에 대한 긴급 소독을 마쳤다고 한다.
시 관계자는 "병원 치료를 받은 학생은 없다"며 "대부분 증상이 호전됐다"고 말했다.
onething@news1.kr
Copyright ⓒ 뉴스1. All rights reserved. 무단 전재 및 재배포, AI학습 이용금지.









